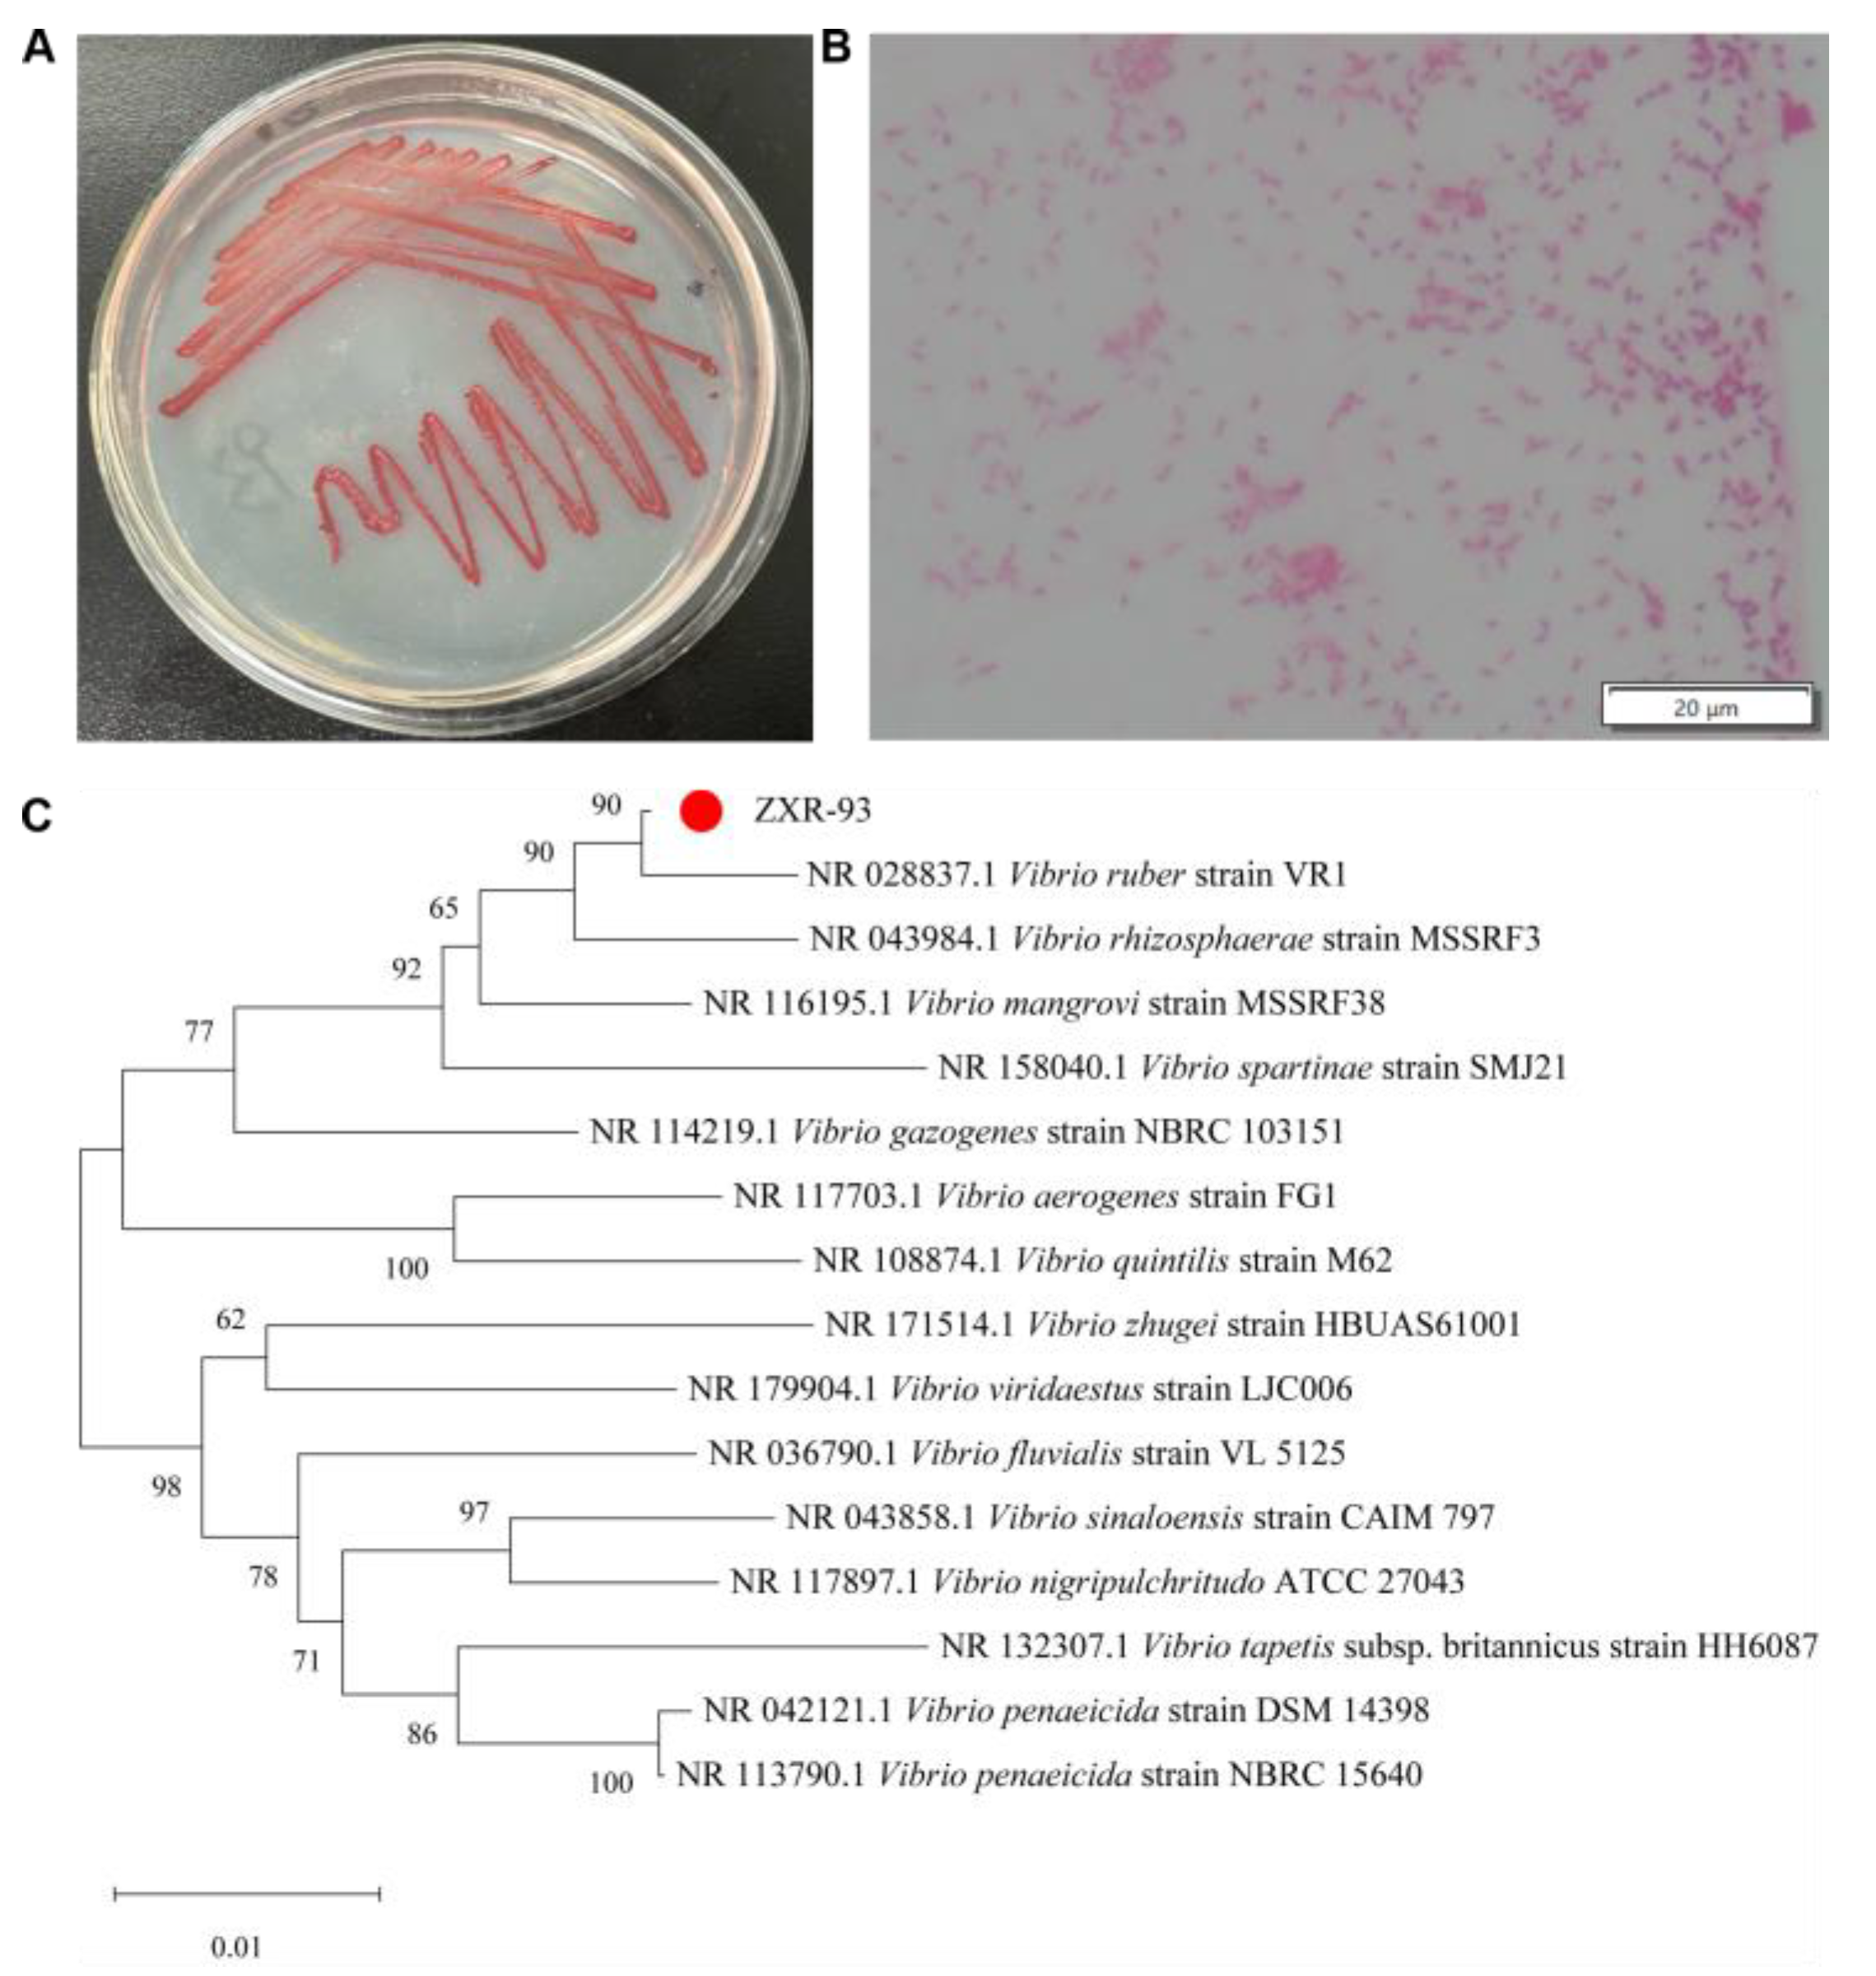
Molecules 29 04446 g002

Abstract
Four new alkaloids, vibripyrrolidine A (1), vibripiperazine A (2), and vibridiazinane A, B (3, 4), comprising one pyrrolidine, one piperazine, and two diazinane alkaloids, along with two known analogs (5, 6), were isolated from the marine bacterium Vibrio ruber ZXR-93 cultured in ISP2 medium. Their chemical structures were elucidated by analysis of their 1D and 2D NMR, mass spectra, and electronic circular dichroism (ECD) calculations. Compounds 1 and 3–6 showed vigorous antibacterial activity against Staphylococcus aureus, with MIC values ranging from 0.96 to 7.81 μg/mL. Moreover, compound 1 exhibited robust anti-inflammatory activity in vitro using the LPS-induced RAW264.7 macrophage model. All compounds also showed moderate antineoplastic activity against cervical cancer cells (HeLa) and gastric cancer cells (SGC-7901).
1. Introduction
There is an urgent need for novel and biologically active natural products to tackle the emergence of drug-resistant strains and treat various diseases that endanger human and animal health [1]. Given the constraints of land resources, we are increasingly focusing on the marine environment, which offers a more complex ecosystem and a wealth of possibilities [2]. The natural products derived from marine bacteria have been proven to possess a range of remarkable biological activities, including antibacterial [3], anti-inflammatory [4], anticancer [5], and antitrypanosomal [6] properties. These fascinating compounds are an invaluable source of novel lead drugs, offering immense potential for developing innovative therapeutic agents [7]. With their diverse and remarkable properties, marine bacteria-derived natural products are vital to unlocking the secrets of nature’s medicinal wonders [8,9,10].
Intending to discover novel natural products derived from marine bacteria, our initial step involved the isolation of cultivable marine bacteria from samples gathered from coastal habitats. Subsequently, we screened to identify strains exhibiting antibacterial and antitumor activities, prioritizing those demonstrating robust activity for further isolation and identifying their secondary metabolites. Through months of diligent research, we successfully isolated a marine bacterium, Vibrio ruber ZXR-93, from the coastal seawater of Haikou City, China, which exhibited significant antibacterial and antitumor activities. We then proceeded to investigate the secondary metabolites of this strain. Investigation of this bacterium cultured in ISP2 medium led to the isolation of one new pyrrolidine derivative—vibripyrrolidine A (1), one new piperazine derivative—vibripiperazine A (2), and two new diazinane derivatives—vibridiazinane A (3) and vibridiazinane B (4). Two known compounds, 1, 2-diethyl-diazinane (5) and tetraethyl hydrazine (6), are also isolated (Figure 1). All isolated metabolites (1–6) were evaluated for their antibacterial, antineoplastic, and anti-inflammatory activities in vitro, providing valuable insights into their potential therapeutic applications.
Figure 1.
Chemical structures of compounds 1–6.
2. Results and Discussion
The colonies of the ZXR-93 strain on ISP2 solid medium were red, small, and round, relatively wet, with flat edges and smooth surfaces (Figure 2A). Under the watchful eye of an optical microscope, gram staining revealed the bacterium’s morphological characteristics. It was an arc-shaped, gram-negative, produced nondiffusible, cellular red pigments (Figure 2B). The 16S rDNA sequence (1464 bp; for the detailed sequencing data, see Supporting Materials) was a perfect match with the Vibrio ruber sequence (KY047409.1) on GenBank, sharing a homology of 99.9% (Figure 2C). Thus, this marine bacterium was identified as Vibrio ruber.
Figure 2.
Identification of the strain ZXR-93. (A) colony morphology on a solid medium; (B) gram staining observed under a 100× light microscope; (C) the phylogenetic tree constructed by the strain and other bacteria.
Compound 1 was obtained as a red powder. Its molecular formula was established as C22H33NO5 (requiring seven degrees of unsaturation) based on high-resolution mass spectral (HR-ESIMS) analysis, which yielded a protonated molecule at m/z 392.2428 [M + H]+ (calcd for C22H34NO5, 392.2437). The 1H and 13C NMR data (Supplementary Materials Table S1) with HSQC spectrum revealed the existence of a carbonyl carbon (δC 171.7), seven doublet olefinic or aromatic signals at δH 7.29 (m), 7.07 (d, J = 8.5 Hz), and 6.72 (m), three oxymethines, three C–N carbons, three methynes, three methylenes, and three methyls. The planar structure of 1 was established through the analysis of HMBC spectra (Figure 3). HMBC correlations from H-8 [δH 3.65 (d, J = 6.9)] to C-2′ and C-5′ suggested the pyrrolidine ring was positioned at C-8. Also, HMBC correlations from H-13 (δH 3.64) to C-11, C-15, and C-17 and H-14 (δH 3.53) to C-12 and C-16 confirmed the presence of the 4-methylhex-1-ene structure. The relative configuration of 1 was determined using NOESY spectroscopy (Figure 4). Since the J value of H-11 is 8.5, the structure of the olefin C11-12 is cis, and the ROESY observed between H-11 and H-13 and H-12 and H-17 indicated that the configuration of C-14 is R-structure. NOESY correlations from protons of the benzene ring (H-2/-3/-4/-5) to H-7, H-8, H-2′, and H-3′, and from H-6′ to H-12 and H-17, suggested the relative configuration of 1 as 7R, 8R, 14R, 2′S, 3′R, 4′R. Finally, the absolute configuration 1 was determined by comparing the calculated and experimental ECD spectra. It was discovered that there was a good match between the experimental spectrum and the expected ECD spectrum of (7R, 8R, 14R, 2′S, 3′R, 4′R)-1 (Figure 5). Thus, the absolute configuration of 1 was established with the absolute configuration of 7R, 8R, 14R, 2′S, 3′R, 4′R and named vibripyrrolidine A.
Figure 3.
Key HMBC (black arrow) correlations of compounds 1–4.
Figure 4.
Key NOE (red arrow) correlations of compounds 1–3.
Figure 5.
Experimental and calculational ECD spectrum of 1–3.
Compound 2 was isolated as a yellow powder. Its molecular formula was determined to be C12H18N2O3 based on the HR-ESIMS ion at m/z 239.1335 [M + H]+ (calcd for C12H19N2O3, 239.1396), indicating five degrees of unsaturation. The 1H and 13C NMR data (Table S1) with HSQC spectrum showed the presence of two carbonyl carbons (δC 171.3 and 167.7), two oxymethines [δC 69.9, δH 3.50 (m); δC 65.9, δH 4.16 (q, J = 6.9)], four C–N carbons, two methylenes, and two methyls. These spectroscopic features suggested that 2 belongs to the family of diketopiperazine and is very similar to Cyclo (L-Ala-L-Pro), which was usually obtained from the culture of marine-derived microorganisms and was reported to have the 5S and 9S configurations [11]. The significant differences between these two compounds were that the former added two oxymethines, one C–N carbon, and one methyl. The HMBC correlations (Figure 3) from H-2 [δH 3.50 (m)] to C-5, C-6, and C-15, from H-3 [δH 3.49 (m)] to C-5, C-6, and C-14, from H-5 [δH 4.23 (m)] to C-2 and C-3, and from H-6 [δH 4.16 (q, J = 6.9)] to C-2 and C-3, suggested that the six ring in 2 was formed by the connection between C-2 and C-6 via an oxygen atom. Besides, the NOESY spectrum (Figure 4) showed correlations from H-5 to H-14 and H-15, H-2 to H-3, and H-9 to H-6, which suggested that the relative configuration of 2 was 2R, 3R, 5S, and 9S. Combined with its CD spectrum (Figure 5), structure 2 was finally determined with the absolute configuration of 2R, 3R, 5S, and 9S and named vibripiperazine A.
Compound 3 was obtained as a yellow amorphous solid. Its molecular formula was determined to be C7H16N2 based on the HR-ESIMS ion at m/z 129.1379 [M + H]+ (calcd for C7H17N2, 129.1392), indicating one degree of unsaturation. The 1H and 13C NMR data (Table S1) with the HSQC spectrum showed the presence of two methyl groups, two methylenes, and three C-N carbons. The 1D NMR data of 3 were similar to those of a known compound that was also isolated from this strain, 1,2-diethyl-diazinane (5, which we named vibridiazinane C), except for the presence of an additional methyl group and the lack of a diethyl group in 3. The HMBC correlations (Figure 3) from H-9 [δH 1.29 (d, J = 7.9)] to C-4, C-5, and C-7 suggested that the additional methyl group was positioned at C-6. Also, the NOESY spectrum (Figure 4) showed correlations from H-6 to H-5 and H-7 and H-9 to H-3 and H-4, which indicated that the relative configuration of 3 was 6R. Finally, its absolute configuration was determined to be 6R by the ECD calculated and experimental spectrum (Figure 5) and named vibridiazinane A.
Compound 4 was also obtained as a yellow powder. Its molecular formula was determined to be C5H12N2O based on the HR-ESIMS ion at m/z 117.1051 [M + H]+ (calcd for C5H13N2O, 117.1028), requiring one degree of unsaturation. The 1H and 13C NMR data suggested that structure 4 is similar to vibridiazinane A (3). The significant difference was the presence of an oxymethine group and the lack of a methyl group in 4. The one-dimensional (1D) and two-dimensional (2D) NMR data analysis unambiguously accomplished detailed assignments for proton and carbon signals (Table S1). In the HMBC spectrum, correlations from H-6 to H-4 and H-7 suggested a connection between N-2 and C-4 via an oxygen atom. The structure of 4 was given the trivial name vibridiazinane B.
The structures of the known compounds 1, 2-diethyl-diazinane (5), and tetraethylhydrazine (6) were identified based on their 1H-NMR, 13C-NMR, and ESIMS data and by comparison to the reported spectroscopic data [12,13].
The antibacterial activities of the isolated compounds 1–6 were evaluated against four pathogenic bacteria: Escherichia coli, Klebsiella pneumonia, Pseudomonas aeruginosa, and Staphylococcus aureus. As shown in Table 1 and Figure S1, most of the compounds (1, 3–6) had strong antibacterial effects on S. aureus, with MIC values ranging from 0.96 to 7.81 μg/mL, and their antibacterial effects were comparable to those of the positive control penicillin. In addition, compounds 3 and 5 had weak inhibitory effects on K. pneumonia and E. coli, but none of the compounds exhibited an antibacterial effect against P. aeruginosa.
Table 1.
Diameter of inhibiting bacteria circle (DIBC, mm) and MIC (μg/mL) of compounds.
The antineoplastic activities of the isolated compounds were also evaluated. The cytotoxicity of these compounds to gastric cancer cell SGC-7901, cervical cancer cell HeLa, and normal gastric mucosa cell line GES-1 was determined using an MTT assay. The results indicate that all compounds exhibit moderate antineoplastic activity against these two tumor cells but weak inhibition proliferation for normal GES-1 cells (Table 2, Figure S2). The observed cytotoxicity is concentration-dependent, with higher compound concentrations resulting in more significant inhibition of cell proliferation.
Table 2.
IC50 values of compounds against three cell lines (μg/mL).
The anti-inflammatory activities of 1–6 were measured by accessing their influence on nitric oxide (NO) production in RAW264.7 cells induced by lipopolysaccharide (LPS). As demonstrated in Figure 6, most of the compounds (2–6) showed weak or no anti-inflammatory activity except for Vibripyrrolidine A (1), which revealed anti-inflammatory solid activities, with inhibition rates of 86.87% and 94.48% at concentrations of 1.0 and 2.0 µg/mL. Additionally, the cytotoxicity of these compounds on RAW264.7 cells was evaluated (Figure S3). At concentrations of compound 1–3 below 2 μg/mL and concentrations of compound 4–6 below 8 μg/mL, there was no significant difference in cell viability between the compound and the control group, indicating that these concentrations are non-toxic to cells.
Figure 6.
Effects of compounds on NO secretion in RAW264.7 cells. Statistical significance was determined versus the control group (one-way ANOVA followed by a Student’s t-test), * p < 0.05, *** p < 0.0001.
3. Materials and Methods
3.1. General Experimental Procedures
ElectroSpray ionization-mass spectrometry (ESI-MS) was recorded on an AB Sciex API4000 mass spectrometer. Nuclear magnetic resonance (NMR) spectra were recorded on Bruker AV 400 MHz spectrometers with tetramethyl silane (TMS) as an internal standard. U.V. spectra were obtained on a ThermoFisher (Waltham, MA, USA) Evolution 201/220 spectrophotometer. CD spectra were recorded on a Bio-logic MOS500 circular dichroism spectrometer. Thin-layer chromatography (TLC) and precoated TLC plating were performed on SiO2 GF254 (10–40 mm, Qingdao Marine Chemical Inc., Qingdao, China). Column chromatography was performed on silica gel (SiO2: 200–300 mesh, Qingdao Marine Chemical Inc., Qingdao, China) and analytical high-performance liquid chromatography (HPLC): RP-18 (LaChrom C18 (4.6 × 150 mm) L-2000, Hitachi Co., Tokyo, Japan).
3.2. Bacterial Identification
The bacterium (strain ZXR-93) was isolated from the coastal seawater of Xinbu Island, Haikou City, Hainan Province, China (110°35′496″ E, 200°7′776″ N). Gram staining was executed using a gram staining kit (Biotechnology Co., Ltd., Shenyang, China). The staining process involved using Gentian purple for primary dyeing, iodine for mordant dyeing, a decolorization solution for decolorization, and safranin for redyeing. The morphology of bacteria was observed under a 100× oil microscope. The chromosomal DNA of the ZXR-93 strain was extracted using a bacterial genomic DNA extraction kit (Sangon Co., Shanghai, China), and the 16S rDNA fragment was amplified using a PCR kit. The PCR system consisted of 1 μL of template DNA (20–50 ng/μL), 0.5 μL of sense-27 F primer (AGTTTGATCMTGGCTCAG, 10 μM), 0.5 μL of antisense-1492 R primer (GGTTACCTTGTTACGACTT, 10 μM), 15 μL 2 × PCR Mix (Tiangen Co., Beijing, China), and double-distilled water. The PCR procedure was as follows: predenaturation at 94 °C for 5 min, denaturation at 94 °C for 45 s, renaturation at 55 °C for 45 s, extension at 72 °C for 60 s, cycle 30 times, and extension for an additional 10 min. Sangon Co. sequenced the PCR products, and the obtained 16S rDNA sequences were compared on the NCBI website. The phylogenetic tree was drawn after analysis by MEGA 11 software.
3.3. Fermentation, Extraction and Isolation
The bacterium was grown under revolving conditions at 28 °C, 180 rpm, for two days in 1000-mL Erlenmeyer flasks containing liquid ISP2 medium (5 g/L maltose, 4 g/L yeast powder, 4 g/L peptone, 35 g/L crude sea salt, 300 mL/flask). The fermentation broth (150 L) was divided into bacteria and supernatant by centrifugation. The supernatant was extracted with ethyl acetate 3–5 times to give an ethyl acetate solution, while the bacteria were extracted with methanol 3–5 times. Both solutions were combined and concentrated to give a crude extract (24.17 g). The crude extract was eluted on a silica gel column by gradient elution of CH2Cl2-MeOH (0–100%) to obtain 42 fractions (Fr.1-Fr.42). Fr.11 was isolated and purified twice by preparative TLC using MeOH-CH2Cl2 (1:20) and CH2Cl2-EtOAc-CHCl3 (3:2:1) as developing agents to yield compound 1 (20.1 mg, Rf = 0.45). Fr.18 was separated twice by preparative TLC with MeOH-CH2Cl2 (1:20) and EtOAc-CHCl3-nBuOH (5:5:1) to produce compound 2 (13.2 mg, Rf = 0.78). Fr.22 was subjected twice to preparative TLC by n-Hexane-CH2Cl2-MeOH-triethylamine (2:10:3:1) and acetone-triethylamine (7:1) to provide compounds 3 (19.8 mg, Rf = 0.63), 5 (47 mg, Rf = 0.21), and 6 (11.6 mg, Rf = 0.85). Compound 4 (6.7 mg, Rf = 0.34) was isolated from Fr.39 by preparative TLC using MeOH-CH2Cl2 (1:5) as a developing agent.
- Vibripyrrolidine A (1): red powder, [α]D 25 + 33.7 (c 0.15, MeOH); ECD (0.025 mM, MeOH) λmax (Δε) 232 (−0.98) nm, 275 (3.57) nm, 325 (2.66) nm; U.V. (MeOH) λmax (log ε) 225 (1.60), 284 (0.66), 499 (0.79), 534 (1.29); 1H NMR (CD3OD, 400 MHz) and 13C NMR (CD3OD, 100 MHz), for data, see Table S1; HR-ESIMS m/z 392.2428 [M + H]+ (calcd for C22H34NO5, 392.2437).
- Vibripiperazine A (2): yellow powder, [α]D 25 − 16.4 (c 0.15, MeOH); ECD (0.042 mM, MeOH) λmax (Δε) 227 (−1.21) nm, 315 (0.43) nm; U.V. (MeOH) λmax (log ε) 207 (2.28), 260 (0.52); 1H NMR (CD3OD, 400 MHz) and 13C NMR (CD3OD, 100 MHz), for data, see Table S1; HR-ESIMS m/z 239.1335 [M + H]+ (calcd for C12H19N2O3, 239.1396).
- Vibridiazinane A (3): yellow crystal, [α]D 25 − 6.5 (c 0.15, MeOH); ECD (0.078 mM, MeOH) λmax (Δε) 215 (−1.12) nm; U.V. (MeOH) λmax (log ε) 215 (3.22); 1H NMR (CD3OD, 400 MHz) and 13C NMR (CD3OD, 100 MHz), for data, see Table S1; HR-ESIMS m/z 129.1379 [M + H]+ (calcd for C7H17N2, 129.1392).
- Vibridiazinane B (4): yellow powder, U.V. (MeOH) λmax (log ε) 210 (2.33); 1H NMR (CD3OD, 400 MHz) and 13C NMR (CD3OD, 100 MHz), for data, see Table S1; HR-ESIMS m/z 117.1051 [M + H]+ (calcd for C5H13N2O, 117.1028).
3.4. ECD Calculation
The theoretical ECD spectra of compounds 1–3 were calculated using the Gaussian-23 software tool. Conformational analysis and density functional theory calculations were used to generate and optimize conformations at the B3LYP/6-311G level of theory, following the previously described procedure [14].
3.5. Antibacterial Assay
The pathogenic bacterial strains Escherichia coli ATCC 8739, Klebsiella pneumonia HMCP 805734, Pseudomonas aeruginosa HMCP 807623, and Staphylococcus aureus ATCC6538 were purchased from the National Institute for the Control of Pharmaceutical and Biological Products (Beijing, China). The specific antibacterial assay was carried out as described previously [15].
3.6. Cytotoxicity Assay
The human gastric cancer cell line SGC-7901, cervical cancer cell line HeLa, and the normal gastric mucosa cell line GES-1 were obtained from ATCC (Manassas, VA, USA). The cytotoxic activity against the SGC-7901, HeLa, and GES-1 cell lines was determined according to the MTT method [16].
3.7. Anti-Inflammatory Assay
The mouse leukemic monocyte macrophage cell line RAW 264.7 was also purchased from ATCC. The MTT assay detected the effects of these compounds on the cell viability of RAW264.7 cells. The safe concentration was selected to detect the impact of the compound on NO secretion in LPS-stimulated inflammatory cells [17].
Supplementary Materials
The following supporting information can be downloaded at https://www.mdpi.com/article/10.3390/molecules29184446/s1: The antibacterial activity, anti-inflammatory activity, cytotoxic activity, and complete spectroscopic data for compounds 1–6 (PDF).
Author Contributions
X.Z., Y.T. and S.Z. performed the isolation and structure determination of the compounds and wrote the manuscript. Y.L. and H.Z. performed the cytotoxic, anti-inflammatory, and antimicrobial bioassays. All authors have read and agreed to the published version of the manuscript.
Funding
This study was supported by the Hainan Province Science and Technology Special Fund (Grant No. ZDYF2023SHFZ114), the Hainan Provincial National Natural Science Foundation of China (Grant No. 522RC684), and the National Natural Science Foundation of China (Grant No. 82460757).
Institutional Review Board Statement
Not applicable.
Informed Consent Statement
Not applicable.
Data Availability Statement
The original data presented in the study are included in the article/Supplementary Materials; further inquiries can be directed to the corresponding author.
Conflicts of Interest
The authors declare no conflicts of interest.
References
- Carroll, A.R.; Copp, B.R.; Davis, R.A.; Keyzers, R.A.; Prinsep, M.R. Marine Natural Products. Nat. Prod. Rep. 2023, 40, 275–325. [Google Scholar] [CrossRef] [PubMed]
- Atanasov, A.G.; Zotchev, S.B.; Dirsch, V.M.; Supuran, C.T. Natural Products in Drug Discovery: Advances and Opportunities. Nat. Rev. Drug Discov. 2021, 20, 200–216. [Google Scholar] [CrossRef] [PubMed]
- Setiyono, E.; Adhiwibawa, M.A.S.; Indrawati, R.; Prihastyanti, M.N.U.; Shioi, Y.; Brotosudarmo, T.H.P. An Indonesian Marine Bacterium, Pseudoalteromonas rubra, Produces Antimicrobial Prodiginine Pigments. Acs Omega 2020, 5, 4626–4635. [Google Scholar] [CrossRef] [PubMed]
- Shin, H.J.; Heo, C.S.; Anh, C.V.; Yoon, Y.D.; Kang, J.S. Streptoglycerides E-H, Unsaturated Polyketides from the Marine-derived Bacterium Streptomyces Specialis and Their anti-inflammatory Activity. Mar. Drugs 2022, 20, 44. [Google Scholar] [CrossRef] [PubMed]
- Wang, M.; Zhao, H.G.; Hu, J.J.; Xu, Z.; Lin, Y.Y.; Zhou, S.L. Penicilazaphilone C, a New Azaphilone, Induces Apoptosis in Gastric Cancer by Blocking the Notch Signaling Pathway. Front. Oncol. 2020, 10, 00116. [Google Scholar] [CrossRef] [PubMed]
- Takahashi, H.; Iwasaki, A.; Ebihara, A.; Taguchi, R.; Jeelani, G.; Nozaki, T.; Suenaga, K. Isolation of Hennaminal and Isolation and Total Synthesis of Hennamide, Pyrrolinone Compounds from the Marine Cyanobacterium sp. Org. Lett. 2023, 25, 2400–2404. [Google Scholar] [CrossRef] [PubMed]
- Singh, S.B.; Martin, G.E.; Mckittrick, B.; Crowther, J.; Fraenkel, H.; Lunn, C.; Bayne, M.; Perkins, J.B.; Gullo, V. History and Prospects of Drug Discovery and Development Collaboration between Industry and Academia. J. Nat. Prod. 2024, 87, 1235–1245. [Google Scholar] [CrossRef] [PubMed]
- Barbosa, F.; Pinto, E.; Kijjoa, A.; Pinto, M.; Sousa, E. Targeting Antimicrobial Drug Resistance with Marine Natural Products. Int. J. Antimicrob. Agents 2020, 56, 106005. [Google Scholar] [CrossRef] [PubMed]
- Zha, X.; Ji, R.; Zhou, S. Marine Bacteria: A Source of Novel Bioactive Natural Products. Curr. Med. Chem. 2023. [Google Scholar] [CrossRef] [PubMed]
- Zhong, W.M.; Aiosa, N.; Deutsch, J.M.; Garg, N.; Agarwal, V. Pseudobulbiferamides: Plasmid-Encoded Ureidopeptide Natural Products with Biosynthetic Gene Clusters Shared Among Marine Bacteria of Different Genera. J. Nat. Prod. 2023, 86, 2414–2420. [Google Scholar] [CrossRef] [PubMed]
- Yang, Z.D.; Zhang, Y.; Zhao, W.H.; Shu, Z.M. Chemical Composition and Biological Activities of Endophytic Fungus LGT-4, Cultured in CYM Medium. Iran. J. Pharm. Res. 2020, 19, 259–263. [Google Scholar] [PubMed]
- Andrea, S.D.; Zheng, Z.B.; DenBleyker, K.; Joan, C.; Yang, H.; Clark, J.; Taylor, D.; Bronson, J. Synthesis and Antibacterial Activity of Dihydro-1,2-oxazine and 2-Pyrazoline Oxazolidinones: Novel Analogs Of Linezolid. Bioorg. Med. Chem. Lett. 2005, 15, 2834–2839. [Google Scholar] [PubMed]
- Rademacher, P. Method 16: Hydrolysis of Alkylhydrazones. Sci. Synth. 2009, 40, 1163. [Google Scholar]
- O’Brien, S.; Lacret, R.; Reddy, M.M.; Jennings, L.K.; Sánchez, P.; Reyes, F.; Mungkaje, A.; Calabro, K.; Thomas, O.P. Additional Sarasinosides from the Marine Sponge Collected from the Bismarck Sea. J. Nat. Prod. 2023, 86, 2730–2738. [Google Scholar] [CrossRef] [PubMed]
- Zhao, H.G.; Ji, R.; Zha, X.R.; Xu, Z.; Lin, Y.Y.; Zhou, S.L. Investigation of the Bactericidal Mechanism of Penicilazaphilone C on Escherichia coli based on 4D Label-Free Quantitative Proteomic Analysis. Eur. J. Pharm. Sci. 2022, 179, 106299. [Google Scholar] [CrossRef] [PubMed]
- Zha, X.; Ji, R.; Li, Y.; Cao, R.; Zhou, S. Network Pharmacology, Molecular Docking, and Molecular Dynamics Simulation Analysis Reveal the Molecular Mechanism of Halociline Against Gastric Cancer. Mol. Divers. 2024. [Google Scholar] [CrossRef] [PubMed]
- Xu, Z.; Zha, X.R.; Ji, R.; Zhao, H.E.; Zhou, S.L. Green Biosynthesis of Silver Nanoparticles Using Aqueous Extracts of Ageratum Conyzoides and Their Anti-Inflammatory Effects. ACS Appl. Mater. Interfaces 2023, 15, 13983–13992. [Google Scholar] [CrossRef] [PubMed]
Disclaimer/Publisher’s Note: The statements, opinions and data contained in all publications are solely those of the individual author(s) and contributor(s) and not of MDPI and/or the editor(s). MDPI and/or the editor(s) disclaim responsibility for any injury to people or property resulting from any ideas, methods, instructions or products referred to in the content. |
© 2024 by the authors. Licensee MDPI, Basel, Switzerland. This article is an open access article distributed under the terms and conditions of the Creative Commons Attribution (CC BY) license (https://creativecommons.org/licenses/by/4.0/).